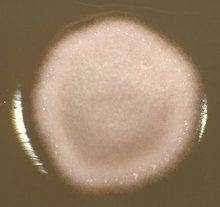
變皮鏈黴菌

基本信息
中文學名變皮鏈黴菌拉丁學名Streptomycesversipellis
參考文獻美國專利2.972.569,1961;Intern.J.Syst.Bacteriol.22:363-364,1972。
形態特徵
孢子絲螺旋形(ISP:孢子絲時常成吸水團)。孢子卵圓形,表面光滑。性狀特徵
變皮鏈黴菌
變皮鏈黴菌形態描述
孢子絲螺旋形(ISP:孢子絲時常成吸水團)。孢子卵圓形,表面光滑。討論
代表菌株:NRRL2528=AbbottM352=ISP5491,分離自美國德克薩斯州甘薯地土樣。放線菌(六)
| 放線菌因菌落呈放線狀而的得名。它是一個原核生物類群,在自然界中分布很廣,主要以孢子繁殖,其次是斷裂生殖。放線菌在自然界分布廣泛,主要以孢子或菌絲狀態存在於土壤、空氣和水中,尤其是含水量低、有機物豐富、呈中性或微鹼性的土壤中數量最多。放線菌只是形態上的分類,不是生物學分類的一個名詞。有些細菌和真菌都可以劃歸到放線菌。土壤特有的泥腥味,主要是放線菌的代謝產物所致。 |
